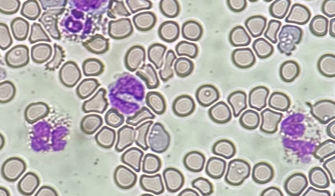
モルモットの血液塗抹.png

更新日:2025.05.24古(いにしえ)の記録 その1
更新日:2025.05.24
古(いにしえ)の記録 その1
リバーサルフィルムをデジタル化してみたの続編です。
また謎の種名を見つけました。
「ヒラリイカエルアタマガメ」です。
カエルなの?カメなの?と思ってしまった私は無知なのか。
ところがこのフィルム、カパラナのような解剖写真ではなく、血液塗抹を顕微鏡で見た写真だったので、本人は写っていなかったのです。
ということで調べてみたところ、カエルではなく、頭がカエルに似ているカメでした。
引用:海老沼 剛著 爬虫類・両生類ビジュアル大図鑑
確かに体はカメですが、頭がカエルっぽいですね。
ということで、スキャンした画像がコチラ。

血液塗抹の顕微鏡写真なので、写っているのは血球です。
いちばん真ん中にある、ややぼんやりしているのが好酸球です。
どうやらこれを撮っておきたかったようですが理由は不明です。
周りにたくさんあるのは赤血球です。カメなどの爬虫類は哺乳類とは違って赤血球にも核があるのです。
ちなみに核があるのは鳥類も同様です。
参考までにこちらが哺乳類であるモルモットの血液塗抹です。
紫の核をもっているのは好中球と好酸球で、そのまわりの白く抜けている細胞たちが赤血球です。
全然違いますよね。
ということでまたネタが見つかったらご紹介したいと思います。
(動物病院 小野)